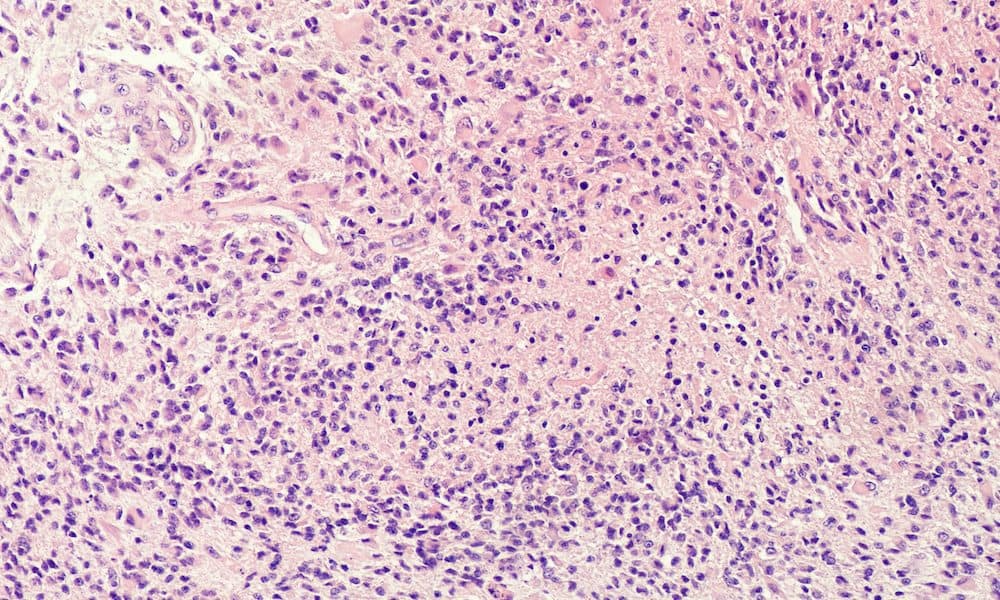
Could this be the long-awaited breakthrough for GBM?

While breakthroughs in cancer treatment over the past 40 years have been truly life-changing, with recovery prospects and life expectancy in many common cancers revolutionised, that sadly is not true with regard to glioblastoma (GBM).
A particularly aggressive form of brain tumour, the outlook for GBM patients continues to be bleak, with the average survival time being just 12 to 18 months despite an intensive treatment regime comprising surgery, chemotherapy and radiotherapy.
Only a quarter of people diagnosed with GBM survive for longer than this, with just five per cent still alive five years later.
In a world where cancer treatments continue to be developed successfully, the overall outlook for most cancer patients is improving accordingly – 76 per cent of breast cancer patients now survive for at least ten years following diagnosis, a rate which has doubled in the last four decades. Sadly, this has not been the case for GBM patients.
And it is that lack of progress in GBM treatment, which has inspired the creation of what just could be the long-awaited breakthrough.
Through the work of QV Bioelectronics, the potential of electric field therapy in helping GBM patients see better clinical outcomes and experience improved quality of life is being realised, with the combination of the biomedical engineering and neurosurgery expertise of its founders, helping to give hope for the future in an area where advances are desperately needed.
“It is too long since we have had any change in how GBM is treated. The needle has moved massively in cancer care, but not in GBM. Our ambition is to increase the number of ‘long term survivors’ significantly – the ones who survive for several years, who currently only make up a very small percentage of all GBM patients,” says Qasim Akhtar, head of business development at QV Bioelectronics.
And with the development of its implantable GRACE device, which would be used alongside the current standard of care, the business is already on its way to delivering on its ambitions.
With a prototype device already made, and ongoing investment being raised to support its progress – with the last £735,000 seed funding round significantly oversubscribed – QV Bioelectronics is striving to be available on the market in late 2028.
Further research and development is ongoing, with pilot studies moving into large animals next year, as QV Bioelectronics continues to move closer to its life-changing technology becoming reality.
The business, established in 2018, was inspired by the experience of Dr Richard Fu, a neurosurgeon who was determined to develop better treatment solutions for GBM patients.
He was aware of the recently developed approach to deliver electric field therapy through an externally worn scalp cap, which had already shown promise in clinical trials, but believed that an implanted approach to deliver electric field therapy continuously and more precisely could have the potential to dramatically improve patient outcomes whilst also improving quality of life.
“Too often, patients were being told they might have a year left. Some of whom were in the prime of their lives, but there was nothing the doctors could do. Patients, and doctors too, were crying out for improved treatments,” says Qasim.
While carrying out research at the University of Manchester, Dr Fu met Dr Christopher Bullock, a biomedical engineer with expertise in medical device design, biomaterials and bioelectronics, who was completing a PhD in regenerative medicine.
“They became fast friends in the lab and the idea took off from there. Chris had huge complementary experience and knowledge in the use of advanced materials in bioelectronics, and the concept drew upon Chris & Richard’s joint expertise,” says Qasim.
“They believed that they could create something highly innovative – an implanted device made from advanced materials which could deliver electric field therapy 24/7 and had the potential to improve survival rates whilst not affecting a patient’s quality of life. This would represent a huge breakthrough.”
And from that concept has come the development of GRACE. After winning the Eli and Britt Harari Award from the University of Manchester in 2018, established to develop commercially-viable ideas using the wonder material graphene, Dr Bullock and Dr Fu used the £50,000 award to begin the process of bringing their idea to life.
From there, QV Bioelectronics – which rebranded from Honeycomb Biotechnology – has continued to develop, with a now six-strong team, of which Qasim was the first employee, and expansion into the UK’s biggest bioscience park, Alderley Park in Cheshire, helping to propel it forward.
Accelerator programmes at Alderley Park, RebelBio (at Imperial College London) and Creative Destruction Lab (at Oxford) have also helped to lay the foundations for its future.
Significant investment has already been raised, but much more will be needed to ensure QV Bioelectronics is able to achieve its ambitions and make its technology available to medical teams and patients.
“We know we’re going to have to raise a lot of investment but we’ve had great support for what we have done so far, and from investors buying into our plans. We need to go through safety clinical trials and major international trials before we can look at securing market approval, the regulations for which are very tight, as they should be,” says Qasim.
“When we go into the studies in large animals in about a year’s time, we hope to show the progress we’ve made with some exciting safety data, and we can move forward from there.”
“It’s amazing to think how far we have come already. When I first joined in 2019, we were working on ideas in co-working spaces and coffee shops, but we are moving forward strongly. There is a huge amount of work to do, but we are all inspired by the end result.”
“Our big ambition is for this to be something that a surgeon recommends whenever a GBM patient has surgery, and for this decision not to be limited by price.
“In the longer-term, we can also look at whether we can expand what we do into other neuro-oncologies, and whether we can integrate detection systems – but for now, the entire focus is on GBM, an area where change is so badly needed.”









